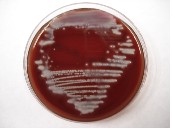

Hello Hello,
I hope that you are doing well. This month we have an article by Dr. Kamash Ramanathan discussing medicinal uses of fungi and another article by Agner Martinez discussing the microorganism Pseudomonas. I hope you find them interesting and useful.
With best wishes,
Dave Gallup
Medicinal Uses of Fungi
By Dr. Kamash Ramanathan, EMLab P&K Northwest Regional Laboratory Director
Most of us have read about the problems associated with fungi and their implications for human health. To give due respect to these amazing life forms let's take a moment to look at their beneficial contribution to human society.
Fungi have been a source of food for numerous generations. Today a huge range of edible fungi (mushrooms) are cultivated in a multimillion dollar industry and savored in many parts of the world. Many food products that we use regularly in our daily lives are processed using fungi. Some common examples include soy sauce processed using Aspergillus oryzae and Saccharomyces rouxii, blue cheese using Penicillium roquefortii, etc. Fungi have also been used in activities such as the control of pests, alcohol and beer production, and making bread. But their importance to humanity is not really appreciated until one studies their usage in drug manufacturing. At the beginning of this century, 10 of the 20 most profitable medicinal products involved fungi. Of the current top-selling prescription medicines, there is the antibiotic amoxicillin (a semi synthetic penicillin which is sold in combination with another compound), three anti-cholesterol statins (pravastatin, simvastatin, and lovastatin), all used to lower plasma lipoprotein levels and an immunosuppressant cyclosporin A, each of which has an annual revenues in excess of 1 billion dollars. All of these are fungal products.
Chemicals derived as part of the life process of one organism that can be used to kill or stop the growth of other microorganisms are referred to as antibiotics. Many of us are here only because an antibiotic called 'penicillin' saved our lives, or the life of one of our parents or grandparents. Penicillin's ability to cure people of numerous bacterial infections has saved so many lives that it is has been referred to as a "miracle drug." In the year 1929, Alexander Fleming, a doctor and researcher, published a paper on a chemical he called 'penicillin', which he had isolated from a mold, Penicillium notatum and noted that it had prevented the growth of a neighboring colony of germs in the same petri dish. Although Dr. Fleming was never able to purify penicillin, he became the first person to publish penicillin's germ-killing power. In the year 1938, Howard Florey, Ernst Chain, Norman Heatley and others expanded on Fleming's work and developed methods for growing, extracting and purifying enough penicillin to prove its value as a drug. This discovery of penicillin marked the beginning of a new approach to treating human disease and established the importance of fungi. Many once-fatal bacterial diseases became treatable, and new forms of medical intervention were possible. The current top five best-selling antibiotics in the world are produced from fungi. Our life expectancy without them would be much lower.
Statins – another class of medically important products derived from fungi – have been recommended for wide spread use to control heart disease. The soil-borne fungi Aspergillus terreus and Aspergillus griseus produce these secondary metabolites statins that have been used to reduce or remove low-density lipoproteins from blood vessels in humans. Statins act on an enzyme in the liver that makes cholesterol. By blocking the enzyme, the body removes cholesterol complexes from the inside of blood vessels. This has the effect of reducing or removing blockages in arteries, and thereby reducing the chance of a heart attack, strokes and diabetes.
A powerful immunosuppressant in mammals referred to as cyclosporin A is a fungal metabolite, and is derived from various fungi including Trichoderma polysporum and Cylindrocarpon lucidum. It is widely used during and after bone marrow and organ transplants in humans. Cyclosporin A acts by binding to various proteins in a manner that suppresses the proliferation of T-cells (responsible for cell-mediated immunity and delayed hypersensitivity). The inhibition of T-cell proliferation results in the suppression of the activation process associated with invasion by foreign bodies. As a consequence, transplant tissues, which are foreign bodies, are not rejected.
There are numerous other medicinal uses of fungi. Ergot, a common name for a fungal disease of certain grains and grasses, is caused by the Ascomycete Claviceps. It produces many alkaloids that have a number of medicinal uses. One of the most widespread uses has been in the treatment of migraines. Griseofulvin, a chemical produced by Penicillium griseofulvum) is the only antifungal agent extracted from fungi. It is fungistatic agent that inhibits fungal growth rather than killing, and is used for the treatment of dermatophytes.
In conclusion, it should be stated that only a few of the possible uses of fungi have been mentioned here. One can say that we have barely scratched the surface of fungi as a source of prevention and cure of diseases and there is potentially a vast range of beneficial use of fungi in the field of drugs and medicine.
References:
1. Gray, William D. The Relation of Fungi to Human Affairs. New York: Henry Holt and Company, Inc., 1959.
2. Lewis, Ricki. "The Rise of Antibiotic-Resistant Infections." FDA Consumer Magazine, 1995.
3. Wainwright, M. An Introduction to Fungal Biotechnology. Wiley, Chichester, 1995.
5. Kimball's Biology Pages: Antibiotics - Antibacterial Agents
6. Fungi as a Platform for New Medicine
Microorganism of the Month: Pseudomonas species
By Agner Martinez, EMLab P&K Analyst
Members of the genus Pseudomonas are found widely as free-living organisms in soils, fresh water, marine environments, and in many other natural habitats. They may also be found in association with plants and animals as normal flora or as agents of disease. Pseudomonas species have the characteristics of being straight or slightly curved, Gram-negative bacilli that are strict aerobes. Most strains are motile by means of one or more polar flagella; they utilize glucose and other carbohydrates oxidatively, and are usually cytochrome oxidase-positive.
Pseudomonas aeruginosa growth on Tryptic Soy Agar (TSA) plate.
Copyright © EMLab P&K
|
|

Gram stain of Pseudomonas aeruginosa.
Copyright © EMLab P&K
|
The current classification divides the family Pseudomonaceae into 5 groups based on ribosomal RNA (rRNA)/DNA homology. Although most members of this family were originally classified in the genus Pseudomonas, it is now known that each of the five rRNA groups represent taxonomically distinct genetic groups, and as result different genus names have been assigned to each of the rRNA groups. Only the members of rRNA group I retain the genus designation of Pseudomonas.
Pseudomonas aeruginosa is the type species of the genus, and is one of the most commonly encountered gram-negative organisms. Other significant species in the genus include, Pseudomonas fluorescens, Pseudomonas putida, Pseudomonas stutzeri, Pseudomonas mendocina, Pseudomonas alcaligenes, Pseudomonas pseudoalcaligenes, Pseudomonas species CDC group, among others.
Pseudomonas aeruginosa can be found in soil, water, plants, as well as in domestic environments such as, hot tubs, whirlpools, contact lens solutions. In hospital environments can be present in sinks, showers, respiratory equipment, etc. Although this organism is an environmental inhabitant, it is also a very successful opportunistic pathogen. Factors that contribute to the pathogenicity include production of exotoxin A, which kills host cells by inhibiting protein synthesis, and production of several proteolytic enzymes and hemolysins that destroy cells and tissue.
Pseudomonas fluorescens and Pseudomonas putida occur in water and soil and may be present in water sources in the hospital environment. Both may exist as normal pharyngeal flora and are rare opportunistic pathogens in humans. Two phenotypic characteristics that distinguish Pseudomonas fluorescens from Pseudomonas putida are its ability to grow at 4°C and to hydrolyze gelatin. These characteristic help explain its frequent involvement in spoilage of refrigerated food, in particular chicken and processed food.
Psedomonas stutzeri is ubiquitous in soil and water and has been recovered from manure, straw, sewage, stagnant water, baby formula, hospital equipment, eye cosmetics, machining fluids, and various clinical specimens. It has only rarely been associated with infections, and its pathogenic properties have not been clearly demonstrated. Freshly isolated colonies can usually be identified by their appearance, which is wrinkled and adherent.
Pseudomonas mendocina is related to Pseudomonas stutzeri, and is rarely isolated from clinical specimens. The colonies are flat and smooth, and have the appearance and consistency of butter.
Pseudomonas alcaligenes, Pseudomonas pseudoalcaligenes, and Pseudomonas species CDC group are characterized by being asaccharolytic (not able to metabolize sugars) or only weakly saccharolytic (able to metabolize sugars) in OF glucose medium. Although members of this group are recovered from clinical specimens, their ability to act as human pathogens has only rarely been documented. They are both abundant in the environment, and common in machining coolants.
Pseudomonas species are also known for their ability to metabolize a variety of chemical compounds, including aliphatic and aromatic hydrocarbons, fatty acids, insecticides, and other environmental pollutants. These capabilities make them useful for applications as bioremediation agents. Some species suitable for this purpose include, Pseudomonas alcaligenes, which can degrade polycyclic aromatic hydrocarbons; Pseudomonas mendocina, which is able to degrade toluene; Pseudomonas pseudoalcaligenes is able to use cyanide as a nitrogen source; Pseudomonas resinovorans can degrade carbazole; and Pseudomonas veronii has been shown to degrade a variety of simple aromatic compounds.
A significant number of Pseudomonas can produce exopolysaccharides that are known as slime layers, which contribute to the formation of surface biofilms, complex structures adhering to surfaces that are regularly in contact with water, and harboring colonies of bacteria and usually other microorganisms. Biofilms are protective for the bacteria, and allow them to metabolize unusual nutrients. For example, they have been found in areas where pharmaceuticals are prepared, in antiseptics such as quaternary ammonium compounds and bottled mineral water. Because bacteria associated with biofilms shield themselves in slime, they are more difficult to kill than free-living organisms. It is common to observe a rapid regrowth almost immediately after sanitation, which can be caused by an incomplete removal of the biofilm.
References:
1. Betty A. Forbes, Daniel F. Sahm, Alice S. Weissfeld. 2002. Bailey & Scott's Diagnostic Microbiology, Eleventh Edition: Mosby, Inc, St. Louis, Missouri.
2. Elmer W. Koneman, Stephen D. Allen, William M. Janda, Paul C. Schreckenberger, Washington C. Winn, Jr. 1997. Color Atlas and Textbook of Diagnostic Microbiology, Fifth Edition: Lippincott, Philadelphia, PA.
3. Todar's Online Textbook of Bacteriology: Pseudomonas
4. Wikipedia: Pseudomonas